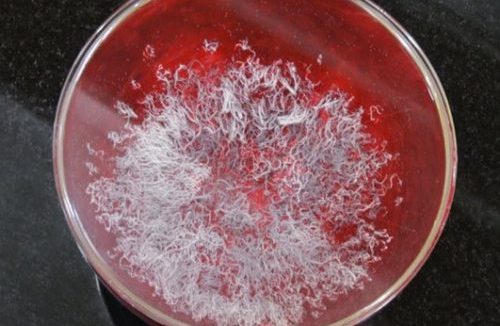

-
-
殊胜成就解脱实例,真正的佛法就在人间
学佛修行的最终目的,是为了脱离六道轮回而成就解脱,住于永恒的幸福祥乐之中。然而解脱成就并不是口头说说或仅靠文字理论就能达到的,那必须要依靠真实的具有解脱力量的如来之法……- 32
- 0
-
佛降甘露恭贺《藉心经说真谛》至宝经典法会
法会开始大概十几分钟,空中突然狂风卷起,呼啸鸣响,诸圣护法驾临,但挂在帷壁上的黄幡缎布,竟然没有吹卷,此时弟子们各自看到了不同的圣境,殊胜无法言喻!……- 21
- 0
-
佛教界为赵玉胜居士举办盛大告别法会-成就圣德
来自国内外数十个佛教寺庙和机构的法师、仁波切、出家人和居士们近200人于9月2日上午聚集在玫瑰岗阿罕布拉的大礼堂,为学习如来佛法成就佛教圣德的赵玉胜居士举行盛大的告别法会……- 26
- 0
-
-
佛弟子赵玉胜接受了真实不虚的传法
佛陀恩师观照我的因缘,直接传我无上殊胜的大法,请来本尊南无阿弥陀佛亲自来为我摸顶、来告诉我,并安排中品中升,让我吃了个定心丸!我放下了心里的一切包袱!我没有挂碍了……- 10
- 0
第三世多杰羌佛
❯
搜索
扫码打开当前页
返回顶部
幸运之星正在降临...
点击领取今天的签到奖励!
恭喜!您今天获得了{{mission.data.mission.credit}}积分
我的优惠劵
-
¥优惠劵使用时效:无法使用使用时效:
之前
使用时效:永久有效优惠劵ID:×
没有优惠劵可用!